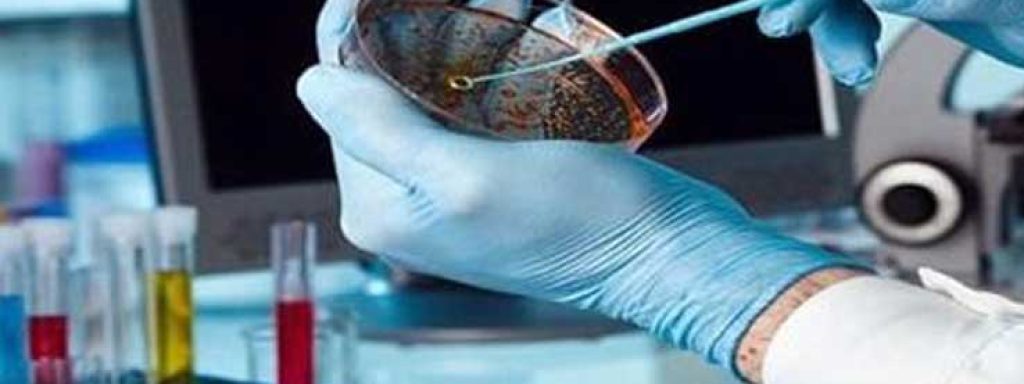

The Microbiology Laboratory at Pars Lian Arvand plays a vital role in ensuring the safety and quality of various products by detecting and analyzing microorganisms such as bacteria, fungi, and yeasts. These microorganisms can pose serious health risks if present in food, sanitary products, textiles, and other consumable
Our laboratory uses advanced equipment and internationally standardized methods to perform a wide range of microbiological tests.
These tests help manufacturers, exporters, importers, and regulatory bodies monitor product safety, prevent disease outbreaks, and improve production processes.
Scope of Testing Includes:
– Food products (dairy, meat, baked goods, etc.)
– Cellulosic and paper-based materials
– Sanitary and hygiene products
– Beverages and bottled drinks
– Non-woven fabrics and textiles
– Cosmetic products
With ISO/IEC 17025 accreditation covering 33 specific microbiological tests, we guarantee
high precision, accuracy, and compliance with both national and international standards.
| Test Method Title | Iran Standard | Test Method Number | Download |
|---|---|---|---|
| Microbiology of cereals and pulses grains - Specifications and test methods | ISIRI 11602 | Download | |
| Sterilization of medical devices-Test of sterility Part 1:Direct method | 1-3001 INSO | Download | |
| Cellulose products - non-sterile hydrophilic cotton - characteristics nd microbiological test methods | ISIRI 7274 | Download | |
| Microbiology of diaper and sanitary towel -Specifications and test methods | ISIRI 1830-2 | Download | |
| Microbiology of diaper and sanitary towel -Specifications and test methods | ISIRI 1830-2 | Download | |
| Microbiology of diaper and sanitary towel -Specifications and test methods | ISIRI 1830-2 | Download | |
| Microbiology of diaper and sanitary towel -Specifications and test methods | ISIRI 1830-2 | Download | |
| Microbiology of diaper and sanitary towel -Specifications and test methods | ISIRI 1830-2 | Download | |
| Microbiology of diaper and sanitary towel -Specifications and test methods | ISIRI 1830-2 | Download | |
| Microbiology of diaper and sanitary towel -Specifications and test methods | ISIRI 1830-2 | Download |